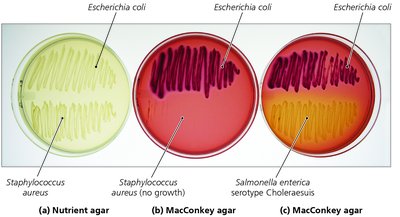
MacConkey agar and nutrient agar with different bacteria

BackMicrobial Nutrition and Growth: Culturing and Measuring Microbial Populations
Study Guide - Smart Notes
Tailored notes based on your materials, expanded with key definitions, examples, and context.
Microbial Nutrition and Growth
Introduction
This section explores the principles and practices of culturing microbes, the types of culture media, and the methods used to measure microbial growth. Understanding these concepts is essential for microbiology students, as they form the foundation for laboratory work and research in microbial physiology and ecology.
Culturing Microbes
Culture Media
Microbes are grown in the laboratory using a variety of liquid and solid media, each tailored to support the nutritional and environmental needs of different microorganisms.
Nutrient broth: A liquid medium used for general cultivation of microbes.
Agar: A solidifying agent added to media to create solid surfaces for microbial growth, used in pour plates and slant tubes.

Types of Culture Media
There are six general types of culture media, each serving a specific purpose in microbial cultivation and identification:
Defined (Synthetic) Media: Composed of precise amounts of pure chemicals; the exact chemical composition is known.
Complex Media: Contains nutrients from partially digested organic sources (e.g., peptones, extracts); exact composition is not known. Most pathogens are grown on complex media.
Selective Media: Contains substances that favor the growth of particular microbes while inhibiting others.
Differential Media: Allows differentiation of microbes based on visible changes in the medium or colony appearance.
Anaerobic Media: Designed to cultivate anaerobes by excluding oxygen.
Transport Media: Used to maintain and preserve specimens during transport to the laboratory.
Examples of Specialized Media
MacConkey Agar: Selective for Gram-negative bacteria and differential for lactose fermentation. Lactose fermenters produce red-to-pink colonies; non-fermenters form colorless colonies.
Blood Agar: Used for culturing fastidious organisms and differentiating hemolytic patterns:
Alpha-hemolysis: Partial digestion of blood (greenish discoloration)
Beta-hemolysis: Complete digestion (clear zone)
Gamma-hemolysis: No hemolysis

Microbial Growth
Mechanisms of Microbial Reproduction
Microbes reproduce by various mechanisms, depending on their group:
Bacteria: Binary fission (asexual reproduction)
Protozoa: Mostly asexual, some sexual reproduction
Fungi: Both sexual and asexual reproduction (budding, spores)

Population Growth and Generation Time
The generation time is the time required for a microbial cell to grow and divide. Bacterial growth is typically logarithmic (exponential), meaning the population doubles at regular intervals under optimal conditions.
Generation time depends on chemical and physical conditions (e.g., nutrients, temperature).


Phases of Microbial Growth
Microbial populations in batch culture typically progress through four distinct phases:
Lag Phase: Cells adjust to new environment; little to no division.
Log (Exponential) Phase: Rapid cell division; population increases logarithmically. Cells are most susceptible to antimicrobial drugs in this phase.
Stationary Phase: Nutrient depletion and waste accumulation balance cell growth and death.
Death (Decline) Phase: Cells die faster than new cells are produced.

Continuous Culture: Chemostats
A chemostat is an open system used to maintain microbial populations in a steady state by continuously adding fresh medium and removing spent medium. This is important in industrial microbiology for maintaining optimal growth conditions.

Measuring Microbial Growth
Direct Methods
Direct methods involve counting cells or colonies to estimate population size:
Microscopic Counts: Cells are counted directly under a microscope using a counting chamber (hemocytometer).
Serial Dilution and Viable Plate Count: Samples are serially diluted and plated; colonies are counted to estimate the number of viable cells in the original sample.
Membrane Filtration: Liquid samples are filtered, and the filter is placed on a growth medium to count colonies.
Most Probable Number (MPN) Method: Statistical estimation based on the number of positive growth tubes at different dilutions.




Indirect Methods
Indirect methods estimate microbial growth by measuring factors correlated with cell number:
Turbidity: Cloudiness of a culture measured with a spectrophotometer; higher turbidity indicates more cells.
Metabolic Activity: Measurement of metabolic products (e.g., CO2, acids) as an indicator of cell number.
Dry Weight: Cells are filtered, dried, and weighed.
Molecular Methods: Detection of specific DNA sequences; rapid and does not require culturing.

Key Terms and Concepts
Inoculum: A sample of microbes introduced into a growth medium.
Culture: Microbes that grow and multiply in or on a culture medium.
Specimen: A sample taken from a site for analysis.
Sample Calculations
Population Doubling Example
If a flask is inoculated with 100 cells/ml and the generation time is 1 hour (no lag phase), the population doubles every hour:
1 hr: 200 cells/ml
2 hr: 400 cells/ml
3 hr: 800 cells/ml
4 hr: 1,600 cells/ml
5 hr: 3,200 cells/ml
6 hr: 6,400 cells/ml
It will take 6 hours to exceed 6,000 cells/ml.
Summary Table: Types of Culture Media
Type of Media | Main Purpose | Example |
|---|---|---|
Defined (Synthetic) | Exact chemical composition known | Minimal salts medium |
Complex | Contains complex nutrients; composition not fully known | Nutrient broth, blood agar |
Selective | Suppresses unwanted microbes, encourages desired ones | MacConkey agar |
Differential | Distinguishes microbes by colony appearance or media changes | Blood agar |
Anaerobic | Supports growth of anaerobes | Thioglycollate broth |
Transport | Preserves specimens during transport | Stuart's transport medium |
Key Equations
Exponential Growth Equation:
Where: N = final number of cells N0 = initial number of cells n = number of generations
Generation Time Calculation:
Where: n = number of generations t = total time of growth g = generation time
Additional info: This guide expands on the original notes with definitions, examples, and equations to provide a comprehensive overview suitable for exam preparation in a college-level microbiology course.